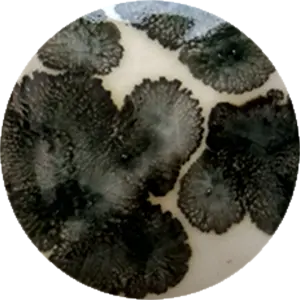
Fantasy Crystal beads cone 04-03 (999 to 1,060'c)

1
/
of
1
Fantasy Crystal beads cone 04-03 (999 to 1,060'c)
Fantasy Crystal beads cone 04-03 (999 to 1,060'c)
Regular price
£8.00 GBP
Regular price
Sale price
£8.00 GBP
Taxes included.
Shipping calculated at checkout.
Enhance your creative projects with Fantasy Crystal beads. These unique beads interact with glazes, resulting in unexpected, captivating effects during application. Their magical properties allow for dynamic and artistic expression, making them an essential tool for artisans seeking innovative outcomes in their work.
Quantity
Couldn't load pickup availability
20 in stock
View full details